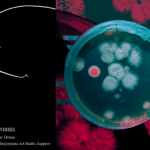
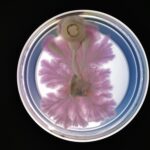

交流スペース展示について
「Networks」プロジェクト情報
プロジェクト紹介
「Networks」は、キノコの栽培とイラストによるストーリーテリングを組み合わせた学際的なプロジェクトです。レジデンス期間中、私たちは6種類の日本産キノコをシャーレの中で育て、それぞれの菌糸がどのように広がり、独自で有機的なパターンを形成していくのかを観察しています。
本プロジェクトは「つながり」のメタファーとして機能しています。
物語はスタジオの共用スペースに設置された連載形式の掲示ボード上で展開され、プロジェクトの進行にあわせて更新されています。これが私たちの呼ぶ「菌糸物語/Mycelium Stories」です。これは制作プロセスをのぞき見るための“窓”となることを意図しています――実際に成長するキノコとフィクションの物語、科学とストーリーが並走する場です。
現在および過去のエピソードは、私のウェブサイト(https://evabodo.art)でもご覧いただけます。
アートと科学は、意味あるものになるために、必ずしも複雑である必要はありません。
“Networks” is a multidisciplinary project that combines mushroom cultivation with illustrated storytelling. Throughout the residency, we are growing six Japanese mushroom species in petri dishes, observing how their mycelium expands into unique, organic patterns.
The project serves as a metaphor for connection.
The story unfolds on a serialized display board in the studio’s common area, updated as the project develops. This is what we called “菌糸物語/Mycelium Stories”. This is meant to serve as a window into the process: real mushroom growth alongside fictional narratives, science alongside story. The current and past episodes of the story can also be followed on my website: https://evabodo.art